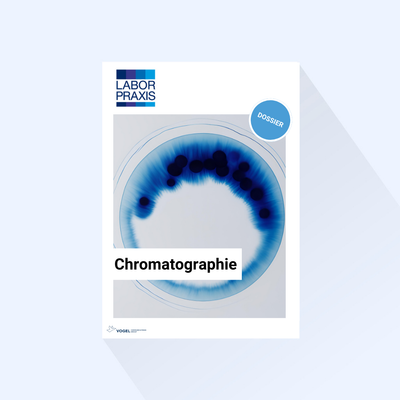

Ausverkauft
- 0%
Ausverkauft
- 0%
Ausverkauft
- 0%
Ausverkauft
- 0%
Lassen Sie uns gerne miteinander sprechen

Nutze die linken/rechten Pfeile, um durch die Slideshow zu navigieren, oder wische nach links bzw. rechts, wenn du ein mobiles Gerät verwendest